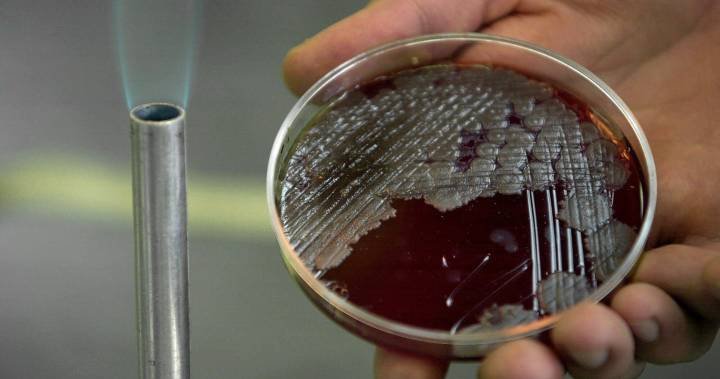

نگاهی به سلاحهای بیولوژيک بخش اول (تاریخچه و مقدمه)
۱) تاریخچه جنگ بیولوژیک به اندازه خود جنگ قدمت دارد و صرفا شکل آن تغییر کرده است. در گذشته طرفین نبرد چاههای آب یکدیگر را آلوده و مسموم میکردند یا تیرهای آلوده به سوی یکدیگر پرتاب میکردند. اولین استفاده ثبت شده از عامل #رشتو
۱) تاریخچه جنگ بیولوژیک به اندازه خود جنگ قدمت دارد و صرفا شکل آن تغییر کرده است. در گذشته طرفین نبرد چاههای آب یکدیگر را آلوده و مسموم میکردند یا تیرهای آلوده به سوی یکدیگر پرتاب میکردند. اولین استفاده ثبت شده از عامل #رشتو
جاري تحميل الاقتراحات...